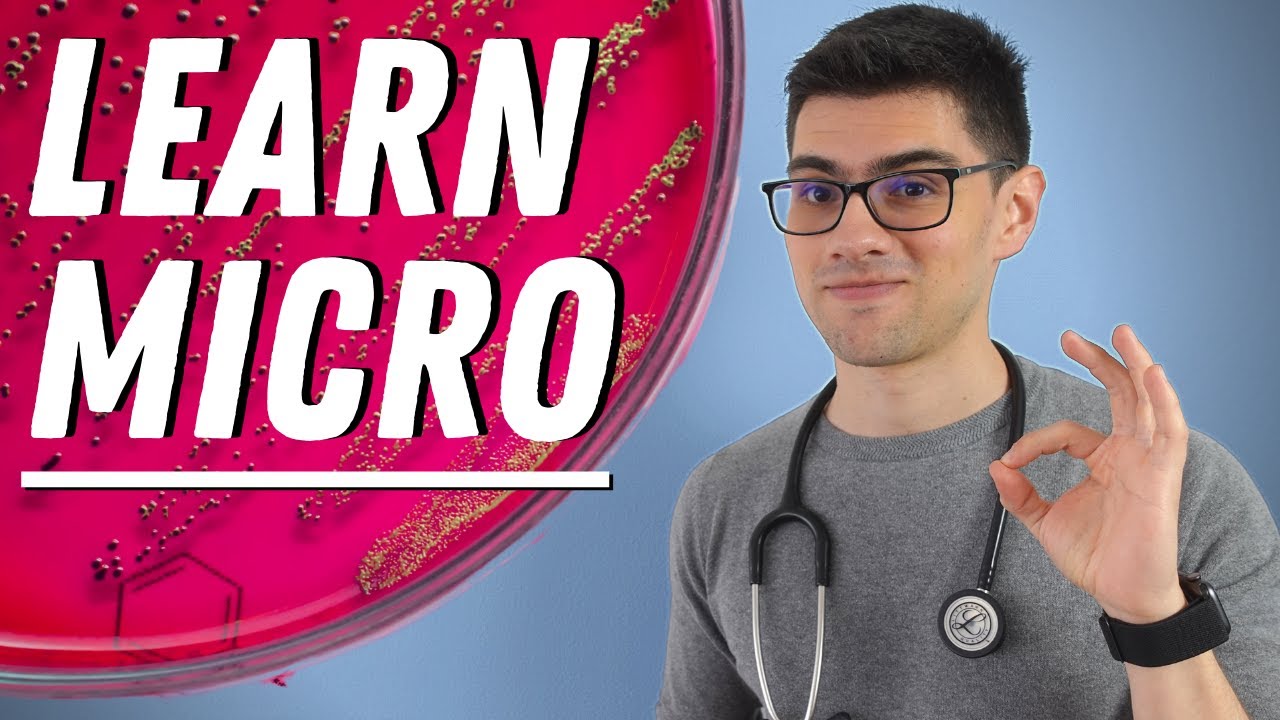

So in this video we're going to talk about an introduction to microbiology history and nomenclature so the first question i have for you is that advertisements tell you that bacteria and viruses are all over your home and that you need to buy antibacterial cleaning products and the question is should you and so what i want you to do is i want you to think about this And we will have a discussion about this in zoom so start thinking about whether or not you think we should use antibacterial cleaning products all over your home are there
maybe instances in which you would want to use those are there reasons not to etc so we are going to start by talking about types of different microorganisms and microbiology is a specialized area of biology that Deals with living things too small to be seen without magnification and so a microbe or a microorganism again would be things that are too small to see with the naked eye so some examples of this would be bacteria archaea protozoans fungi helmets viruses and algae so what you're looking at in this picture is this brown here that is going
to be Human hair and so to give you an idea about comparison what you're looking at is that this big pink looking thing here this is the head of a type of helmet that you guys will learn about in lab that is referred to as taneasolium taneasolium is a pork tapeworm and you can see it has these little hooklets which allow it to grab on to the lining Of the intestine and so if we compare the head of this helmet to other types of microbes what you'll see is here we have fungus so in this
case we're looking at aspergillus and we will again talk about this in our lab about fungi and so we have this aspergillus and so this is the size relative to the helmet and so we have our Protozoans so here's an example of a protozoan we have a red blood cell so this is the rough size of a red blood cell relative to these others and then if you look here this blue is now the fungi blown up and what you can see is that relative to this fungus the bacteria is much much smaller so e
coli for Example is going to be approximately 1 by 2 micrometers in size so it's very very small we are going to talk about archaea and you'll notice that viruses are even smaller viruses you'll learn are acellular meaning they're not made of a cell and they are ultra microscopic you can't even see them with a compound light microscope And so what we're going to look at now is we are going to look at what do these different groups of organisms have in common what do they have as differences so microbes have shaped the development of
the earth's habitat for billions of years the earth is approximately 4.6 billion years ago and so that is when The earth began now in terms of the first living organism the first living organism was believed to have appeared on this planet about 3.8 billion years ago and so that would be our first sign of life now that first sign of life is believed to have been single celled it was a unicellular organism from that last common ancestor we have branched off into three different cell types So we have our eukaryotic cells eukaryotic is referring to
true nucleus those are organisms that have a membrane-bound nucleus that surrounds their dna and then the other two categories are going to be archaea and bacteria both of those types of organisms are single-celled they have no true nucleus they are what we call prokaryotic cells But archaea and bacteria are still distinct from one another and in fact archaea are actually believed to be more closely related to eukaryotic cells than they are to bacteria so we are going to go through and talk about the different characteristics for these different organisms and so we're going to start
with bacteria so bacteria are Prokaryotic again that means these are cells that lack a membrane-bound nucleus so they have no nucleus they have a cell wall and that cell wall is usually made of peptidoglycan now what that means peptido refers to protein glycan refers to sugar so its cell wall is going to be a mixture of protein and sugar you're going to see that that is Distinct from many other types of cell walls in eukaryotic cells for example the cell walls are typically what we call polysaccharide there are many sugars linked together but in bacteria
it's a mixture of protein and sugar and so that makes it unique from eukaryotic cells bacteria exist being unicellular uni think of like a unicycle has one Wheel unicellular means one cell so they exist as one single cell in terms of their reproduction they reproduce by a process called binary fission and what that means is that this is a type of reproduction that is asexual a means without sex meaning without a partner for bacteria they are simply going to just make a copy And divide and so that is asexual reproduction and so bacteria are going
to reproduce asexually in terms of their dna dna you're going to learn is their nucleic acids meaning that that is the way that organisms store genetic information in the case of bacteria their dna is going to be circular so while our dna is linear meaning They're long strands bacterial dna is going to be circular it's a circular piece of dna now in terms of how bacteria get energy that they need all organisms have to be able to take in energy so in the case of bacteria some bacteria are photosynthetic what that means is that they
do photosynthesis and they are what we call autotrophic auto means self trophic is referring to feeder Self-feeder these are organisms that are able to make their own food and so cyanobacteria which is a type of bacteria found in water is an organism that can do photosynthesis just like plants they can take carbon dioxide water and sunlight and convert that into chemical energy in the form of sugar so they are self-feeders they can make their own Sugar other types of bacteria are heterotrophic hetero refers to other trophic as feeder so many bacteria are going to be
heterotrophic they have to consume food in order to survive they're not able to simply just take in and make their own food next we have archaea and archaea are prokaryotic which means Again that they also lack a membrane-bound nucleus so they do not have a nucleus their cell wall lacks peptidoglycan so they do have a cell wall however it is not peptidoglycan it is something that's referred to as pseudomurin so it is like peptidoglycan it is still protein and sugar mix but it's not chemically the same as the peptidoglycan instead it's the pseudo muran archaea
Are unicellular again they reproduce uh by binary fission which again remember is a type of asexual reproduction they also have circular dna just like bacteria do one of the interesting things about archaea is that they tend to be not always but they tend to be what we call extremophiles extreme like it sounds and Then file is lover so they tend to love extreme environments meaning they grow best in these very extreme environments so if we think about a thermophile what would you think a thermophile likes well the answer is the thermophile likes heat these are
heat lovers if we talk about halophiles halo is referring to salt so if you look over on the right you can see this salt Crystal and it has this pink hue on it and that pink hue is a type of organism that is called halobacterium it's not actually a bacteria it's actually an archaea but it it can grow in extreme salinity meaning high salt environments most organisms can't tolerate high salt yet this organism can and it can grow on these salt crystals and so we would call this A halophile or a salt lover so next
we have our methanogens these are going to be our organisms that produce methane which is a gas as a waste product of respiration and so this is just a little bit of information about archaea so now we're going to move on to our eukaryotic organisms meaning these are organisms that the cells are made up of cells that have a nucleus They have this membrane-bound nucleus so the first one fungi fungi are eukaryotic so again their cells have a membrane-bound nucleus cell wall is made of something called chitin chitin is a polysaccharide it's many sugars linked
together so chitin again polysaccharide made of many sugars fungi are heterotrophic they have to consume their food So if you think of things like mold where do you typically think of mold as growing dark damp places right and so what that tells you is that those organisms are not likely to be photosynthetic they're not likely to do photosynthesis because they grow in the absence of sunlight in the case of fungi while they're heterotrophic many are what we refer to as a sap rope it feeds on dead Decaying matter so next if we look at the
way that the cells are arranged they can be unicellular meaning they exist as one single cell and an example of this would be yeast so at the top here we have a type of yeast that is called saccharomyces cerevisiae cerevisiae the name literally means sugar fungus that makes beer this is a type of yeast that is used to Make beer bread and wine and so it's able to do what's called fermentation and so this would be an example of a unicellular fungus so a yeast fungi can also be multicellular in the case of molds and
mushrooms so we have our bread mold for example we have our mushrooms these would be examples of Multicellular types of fungi meaning that they're made of more than one cell in terms of their reproduction they can reproduce sexually or asexually so either with a partner or without so if we look at this bread mold for example it has these types of spores that are used for reproduction and in this case we're looking at what are called sporangiospores notice that we have these sporangium These are these structures that contain the spores and you'll see these little
filaments coming off of them those filaments are referred to as hyphae you can tell by looking at this that this is a sexual reproduction it doesn't involve a partner because only one hyphy is going to the structure so this is going to be something that's used for Asexual reproduction but fungi can do both they can do asexual or sexually in terms of their dna they have linear dna so long strands of dna versus circular and so their dna is going to be these long strands in contrast to bacteria which have circular chromosomes so next we're
going to move on to our protozoans and protozoans are eukaryotic again that Means that they have a membrane-bound nucleus that surrounds the dna these will usually lack cell walls so protozoans are thought to be more kind of animal-like and so in this case these are going to lack cell walls they are usually heterotrophic so again they have to usually consume food in order to survive protozoans are going to be unicellular so they are exist as one single cell You can see on the right here this top picture in the yellow that is amoeba and it
moves by the pseudopods you can see moves by pseudopods basically it does a crawling motion and it can also use pseudopodia to engulf its food so they are going to be unicellular they exist as one single cell they can reproduce either sexually or asexually So again with a partner or without and in terms of their movement again they could move by pseudopods they can move by flagella so these long tail like extensions they could move by cilia which are these tiny hair-like projections that cover the whole surface so a paramecium for example would move using
cilia and then some are going to be non-motile meaning they're not able to move what you're seeing in the bottom here These little purple squigglies that you're seeing that are mixed in with the red blood cells that is a type of organism called trypanosoma and trypanosoma is an organism that can cause what's called african sleeping sickness and african sleeping sickness like the name suggests what ends up happening to patients is that when they have this infection and this infection is heavy meaning There's a lot of these organisms in the blood the organisms are then taking
the host food so if this organism lives in your bloodstream normally the way that your body gets food is that you eat your food you digest it the molecules become small enough they diffuse from your intestines into your bloodstream and then the food is going to circulate through your Bloodstream to the other tissues in your body where that food is going to be used to make atp this organism lives in the blood it can exist in the blood and so what ends up happening is is that when it lives in the blood it's utilizing your
food if it's utilizing your food and you aren't what ends up Happening is is that your cells are unable to make atp they're unable to make energy and so this is why people who have this disease they end up basically going into a coma because their cells don't get the glucose that they need and therefore they don't make the atp and the brain cells stop functioning and so the interesting thing about this Particular organism because most organisms can't survive in the bloodstream because if you think about it in your bloodstream are your white blood cells
which are basically your immune cells those are the cells that fight off foreign invaders so most organisms when they get into your bloodstream they are bombarded by white blood cells which are there to destroy them however Trypanosoma has a unique adaptation in that it does something called antigenic switches it basically is able to change its antigens an antigen is a molecule on the surface of the organism that would normally elicit an immune response meaning it would cause the immune system to respond because it would recognize it as being foreign in this particular organism what it
does Is it has a particular set of antigens we'll call it antigen a the immune system will recognize antigen a as being foreign and the immune system will mount an immune response they'll make antibodies to antigen a but trapanosoma's tricky it mutates it changes its antigens so now antigen a is not on the surface but now it's making antigen b so those antibodies that recognize A those antigens are no longer on the surface now the organism has antigen b on its surface and then it's going to take time for the immune system to recognize it
and to respond and by the time the immune system responds it changes its antigens again so it's almost like it has its disguise and it's able to take off its disguise and now the next layer is exposed and so On and so forth and so this is what allows trypanosoma to be able to live within the bloodstream so now we're going to move on to our algae algae are eukaryotic they have a cell wall with cellulose just like chitin is a polysaccharide cellulose is also a polysaccharide so many sugars linked together just like the cell
wall of fungi Is made of polysaccharide algae are photosynthetic they're able to do photosynthesis they exist as unicellular or multicellular forms so it could exist as either they can reproduce sexually or asexually so they can reproduce with a partner or without and for algae they often contain pigments which Make them appear green red or brown brown algae think of what we typically would refer to as seaweed the seaweed that washes up on the beaches that is a type of algae that's called brown algae it's a type of brown algae now because they are photosynthetic we
should also write that they are also autotrophic they are self-feeders so self-feeders that are able to make their own food now we're going to move on to our Viruses now viruses are a little bit different than everything else we've talked about and that's because viruses are acellular meaning they are not made of cells so again a means without so acellular without cells so because they are a cellular and they're not made of cells cells are the fundamental unit of life and so if they're not made of cells They're not living they're considered to be non-living
and that's because viruses are what we call obligate intracellular parasites obligate means that it's it has to be within the cell so viruses cannot reproduce without a host cell and so the virus has to get into a host cell in order for it to reproduce so like the Coronavirus right now that virus has to infect only particular types of cells only cells that have the appropriate receptor like the cells in the respiratory tract for example and so viruses have to be able to get in and infect a host cell in order for it to reproduce
this is why it's non-living in terms of its genetic information dna or rna but not both Now this is different because our cells and all of the other organisms that i had talked about previously they store their genetic information as dna we store information as dna and rna is used kind of as the messenger but dna is the way that we store it viruses on the other hand can store their genetic information as rna for example coronavirus right the one that's causing covid That is a rna-based virus influenza is an rna-based virus so they have
a different type of genetic makeup they don't store genetic information as dna instead they store it as rna now in terms of viruses viruses can be enveloped or naked enveloped basically means that it has an envelope which is a structure that is made of a cell membrane these are animal viruses and the way That they get that envelope is when they bud off of the animal cell they take some of the animal cell membrane with it now the advantage that gives the virus is that it helps it to evade the immune system because the outside
of the virus looks very much similar to the host cells and so it's more difficult for the host to respond because it's Having a more difficult time recognizing that the virus is within the cells we have a capsid a capsid is a protein coat so viruses are very simple structurally they're typically going to be genetic information so again dna or rna and then that is going to be surrounded by this protein coat this capsid and so viruses lack a lot of or all cellular machinery that living cells Have and so this is what makes viruses
have to be obligate intracellular parasites because they lack those cell machinery they have nucleic acid they have this protein coat but that's pretty much about it in terms of dna or rna notice it says or so it's usually one or the other but not both now there have been examples of viruses that can have Both but it's extremely rare that would be an exception to the rule one of the things that you'll learn about in biology while we can say for example bacteria most have cell walls made of peptidoglycan not all have a cell wall
of peptidoglycan there are always exceptions to the rule there are viruses for example mycoplasma we'll talk about Later it lacks a cell wall doesn't have one but most other bacteria do and so one of the things you'll learn about biology is while we have a rule that usually this is the case like viruses usually the genetic information is dna or rna but not both again there's always going to be exceptions to this rule and then we get to our multicellular animal parasites a Helmet for example a helminth is a worm so we will talk about
this a lot in lab we'll talk about different types of worms but we have our flatworms like our tapeworms for example that's here in the bottom we have our round worms like heartworm for example and so these would be our helmets because they are made Of animal cells they're animals right these worms are animals their cells lack a cell wall so they don't have that rigid cell wall they are heterotrophic they are other feeders animals have to feed in order to survive we can't make our own food these organisms could reproduce sexually or asexually so
with a partner or without and the reason that we're studying these While these worms are actually quite large they do have microscopic stages so they have these microscopic stages and they can cause disease and so this is why we will be talking about these in microbiology as well so question for you which of the following is not a characteristic of bacteria is it red they are prokaryotic yellow have peptidoglycan cell walls green or Multicellular blue reproduced by binary fission purple have the ability to move and when i say have the ability to move i'm referring
to as a group some can be modal and so that's what that's asking so i want you to pause your video think of your answer and when you are ready push play and you can hear the answer so which of those statements is not true of bacteria The answer is going to be green they are multicellular they are not multicellular they are unicellular they exist as one single cell and so the statement saying that they're multicellular is not true for bacteria bacteria are prokaryotic they are made of cells that lack a membrane-bound nucleus they have
peptidoglycan usually in their cell walls They can reproduce by binary fission which again is an asexual type of reproduction and they have the ability to move do they all move no they're not all modal but they do as a group have the ability to move so this next part is something that you are going to do in the discussion we are going to compare and contrast The various types of organisms so for bacteria you would fill this in are they prokaryotic or eukaryotic so you want to go back through your notes and fill in if
that's prokaryotic or eukaryotic for bacteria what is the composition of their cell wall what is their cell wall made of or for certain organisms do they lack a cell wall are they heterotrophic or autotrophic or Both meaning can they be both heterotrophic or autotrophic are they unicellular or multicellular or both meaning they could be either or or asexual reproduction or sexual reproduction or both so i want you to take some time and fill in this table by yourself first and then you will discuss it with a group of people in a zoom meeting and we
will talk about And fill in this table together but you should work on this on your own first and then you will discuss it with a group so now we're going to move on and talk about microbes in our lives how do microorganisms affect our everyday lives so microbes are very easy and very difficult to study and that is because of multiple factors one is that they reproduce rapidly So we can grow bacteria very quickly in culture bacteria like e coli for example reproduce every 20 minutes so that makes them more on the easy side
in order to study they can be grown in large populations in the laboratory again because they reproduce and because they don't take up much space we can culture large amounts of these organisms But what makes them difficult is that they can't be seen directly right because they're microbes they're not visible with the naked eye you have to use a microscope for example to see them so they are usually analyzed through indirect means so either using a microscope or doing what we call biochemical tests to study different aspects of their metabolism Etc and so this is
what macro makes microbes both easy and difficult it has pros it has cons now microbes are ubiquitous and what that means is they're found almost everywhere in nature so where can they be found well they can be found in very diverse environments they could be found deep in the earth's crust they can be found in polar ice caps and in oceans They can be found inside the bodies of plants and animals they can be present in the earth's landscape and they are essential to life and in fact if we read about microbiomes so the types
of bacteria for example that are found in our body what you would find is that our bodies do not function properly without the help of those Microbes those microbes help our body in a variety of ways whether it be digestion etc and so we need those microbes they are act absolutely essential to life now remember that i said that some bacteria for example are photosynthetic they are able to convert solar energy to chemical energy and so this is going to be the light fueled conversion so using sunlight And converting carbon dioxide to organic material so
glucose for example and this can be accompanied by the formation of oxygen meaning that plants for example or cyanobacteria for example when they do photosynthesis they're going to produce oxygen as a byproduct us as animals we need that oxygen to breathe in Because we need oxygen to do cellular respiration and so this oxygen that we breathe in comes from organisms that can do photosynthesis now an oxygenic photosynthesis occurred in bacteria before plants evolved and an oxygenic means without oxygen they do not produce oxygen as a byproduct this is going to be more efficient However in
extracting energy from sunlight but again it doesn't produce oxygen to be put back into the atmosphere oxygenic photosynthesis is evolved from an oxygenic photosynthesis so this is a later form of photosynthesis where basically again they're going to produce oxygen and the photosynthetic microorganisms are responsible for about 70 of the earth's photosynthesis So while we often think of plants as being the major contributor to oxygen in the atmosphere in fact it's actually photosynthetic microbes that produce a variety or the biggest range or the biggest amount of oxygen in the atmosphere so microorganisms are the main forces
that drive the structure and the content of soil water and the atmosphere For example microbes can produce carbon dioxide and no gas we have methane ch3 and these gases are used to help insulate the earth's atmosphere microorganisms are the most abundant cellular organisms in the oceans now notice it doesn't just say the most abundant thing in the ocean viruses are actually More abundant in the ocean than bacteria but bacteria would be the most abundant cellular organisms because remember that viruses are not made of cells so viruses are the most abundant inhabitant of the ocean bacteria
and fungi live in close association with plants and assist them in obtaining obtaining nutrients water and also helps to protect them Against disease and so microbes really play an important role in shaping our planet so some historical uses of microbes by humans we can use microbes to produce bread alcohol right so remember it referred to saccharomyces cerevisiae baker's or brewer's yeast they can do fermentation and they produce alcohol and carbon dioxide which is why yeast is Used in bread it's used to help the dough rise microbes can be used to make cheese for example blue
cheese brie cheese etc microbes can be used to help with treatments of wounds and lesions they can be used to produce antibiotics for example they can be used to mine precious metals they can be used to clean up human created contamination So like an oil spill for example there are microbes that naturally can consume the oil that spills into water and so this bacteria can be put into the water and it can naturally digest and break up the oil that's spilled into the water so when we think about microbes we often need to think about
that they play a role in biotechnology and so there are several ways that they can play a role in biotechnology One is through what's called genetic engineering this is going to manipulate the genetics of the microbes plants and animals for the purpose of creating new products and genetically modified organisms and so they can be used to basically change the dna of a plant for example to make that plant to be more resistant to a particular pest and so that would be Our genetically modified organisms we have recombinant dna technology which makes it possible to transfer
genetic material from one organism to another and deliberately alter the dna so for example the first human recombinant drug to be produced was something that was called humulin this was produced way back in the 80s And humulin is human insulin and so for patients who are diabetic for example if they have type 1 diabetes which is juvenile diabetes what happens in those patients is that they have an autoimmune disease their immune system is going to attack their own cells and specifically in type 1 diabetes their autoimmune disease is actually targeting their pancreatic beta cells It's
a type of cell in the pancreas those pancreatic beta cells of the cells that are responsible for producing insulin insulin is important in your body because when you eat food and your blood sugar goes up right because as you start to digest your food it's going to be absorbed into your bloodstream when it goes into your bloodstream your blood sugar is going to rise In response to that your pancreas is going to secrete it's going to produce insulin and it's going to release insulin into the bloodstream insulin is the signal that tells the cells in
your body hey sugar is available start to take in the sugar into the cells so that the cells can use that sugar to make atp so insulin is essential to basically being able to get glucose into the cells without it glucose can't be transported Into the cell so people who are diabetic they have their pancreatic beta cells that are destroyed so their body is no longer producing insulin and so when they eat sugar for example and their blood sugar starts to rise they don't have that signal that tells their cells to take up glucose and
instead the glucose stays in the bloodstream And so the solution to that is to give these patients injections of insulin when they eat food to help regulate their blood sugar now historically where that insulin had came from previously usually insulin came from one of two places one it could be isolated from cadavers so people who had died they could get Insulin from or it could be used from animals so they could use pig insulin or cattle insulin or other types of animals to produce insulin the problem with that approach is that it's not human insulin
and so some people had adverse reactions to this not normal insulin protein it's a different protein than humans make So the idea then was to take the human insulin gene so the gene the dna sequence for human insulin and you can take that gene and put it into bacteria and you're going to learn that because the genetic code is nearly universal you can take a human dna sequence and put it into bacteria and then bacteria will read that dna sequence And it will make the appropriate protein and so this was used to make this humulin
this human insulin they took the human insulin gene put it into bacteria they could grow the bacteria in these large bioreactors these very large containers and they could produce lots of insulin very quickly and that insulin was human insulin because it was from the human sequence The human gene for human insulin and so that is a type of what we call recombinant dna technology we can have bioremediation this is going to use microbes that are already present or introduced intentionally to restore the stability or cleanup of toxic pollutants so again just like the example of
the oil spill Now while we often think of bacteria we usually have a negative connotation that goes with it meaning we think about them causing disease but what we really need to realize is that the vast majority of microorganisms that are associated with humans are either harmless meaning they have no effect or in fact they are beneficial and so one of the big things that we've started To learn is that in fact bacteria actually are helpful to us and if we get a disruption in what we call our microbiome or the types of bacteria that
are living in our body there are lots of diseases associated with that and so in fact these bacteria in many cases are actually beneficial however there are some that cause disease And if they are a disease-causing organism we refer to that as a pathogen so a pathogen is a microbe that causes disease there are over 2 000 different microbes that cause disease and you're going to learn a lot about those throughout this class 10 billion infections occur across the world every year infectious diseases are among the most Common cause of death worldwide now what you'll
notice is that in the u.s it's not a top form of or not a top cause of death but around the world in fact infectious diseases are definitely still a big problem and they are a leading cause of death so what you're looking at here this is comparing the top causes of death In the united states versus worldwide so you do not have to memorize this table it was just to give you an idea of the differences that the us faces verse versus the rest of the world now if we if they're colored blue blue
indicates that it's not currently known to have an infectious cause meaning that these are things that are causes of death that are not related to infection Notice if you look at the top causes of death so in the u.s the top cause of death is going to be heart disease there's not really an infectious component to that it has more to do with diet lifestyle genetics etc second leading cause of death would be cancer followed by chronic lower respiratory diseases so copd so lung diseases etc accidents Would be number four stroke would be number five
alzheimer's disease is number six diabetes is number seven that was the one i just explained to you number eight now we finally see the first infectious cause of disease in the united states so now we have our influenza and our pneumonia those are infectious causes of disease and then we have kidney disease followed By suicide so that one always surprised me that the number 10 cause of death in the u.s is actually suicide that's pretty crazy if we compare that to worldwide worldwide most common cause of death is still heart disease so that is still
number one in the world the second highest cause of death would be stroke three Would be copd so a lung disease number four lower respiratory infections so notice that again this is going to be associated with the microbe number five respiratory cancers number six hiv and aids which is caused by virus so again that's the infectious cause diarrheal diseases is number seven so in places that have poor sanitation or are not clean water diarrheal diseases can be very fatal and so that is actually number seven That is an infectious cause of disease we have diabetes
then we have road injury followed by hypertension which is basically high blood pressure and so you'll notice that if you look in the world three of the top ten are infectious in the united states however only one of the top ten is infectious and in fact it's only number eight Compared to worldwide it was number four six and seven and so there's this disparity basically in how deadly infectious diseases are if you think about the us we typically have access to we have good sanitation we have clean water we have good access to medical care
and that really is what kind of shapes that the u.s typically doesn't have this high cause Of death due to these infections so there are many microbes and diseases that are either emerging or re-emerging diseases covid that is the perfect example of an emerging disease we have other coronaviruses that have caused disease sars for example we have mers which is middle eastern respiratory syndrome so we have other types of Coronaviruses that have caused disease but we have this new coronavirus which causes us to have covid for example we have aids there's hepatitis c zika virus
which is associated with mosquitoes we have west nile virus we have tuberculosis and so what we see is that we we often are going to see these either brand new diseases showing up Or re-emerging things that were pretty much gone for a while but then re-started to show up again think of when we had a measles outbreak for example there have been found to have associations between non-infectious diseases and microbes and so again this comes down to this human microbiome and that if you get a disruption to that if you get this Disruption in the
types of microbes that are found in the body certain diseases can occur and they're starting to see more of an association between infectious agents and diseases that were previously thought to not have an infectious component an example of this would be gastric ulcers So having an ulcer in your stomach historically wasn't thought to be infectious it was thought to be a product of diet for example of lifestyle etc however we now know that there is a possible infectious component to this as well helicobacter pylori h pylori you guys will learn more about h pylori is
a type of bacteria that can Be found in the stomach and it's able to withstand stomach acid and it can be the infectious cause of ulcers and so ulcers have now been found to also have an infectious component multiple sclerosis obsessive-compulsive disorder coronary artery disease obesity etc these have all been linked to chronic infections with microbes So again diseases that were thought to not be due to anything infectious have now been found to actually have an infectious component to them so we're starting to see some trends in infectious diseases and one trend is that we're
starting to see an increasing number of patients with weakened defenses and what ends up happening is when a patient has a compromised immune system They are then subject to infections by common microbes that are not pathogenic meaning not disease-causing to healthy people and so we call these types of microbes an opportunistic pathogen it's a microbe that if you are healthy your immune system will fight it off and you'll have no problem however in patients who are immunocompromised meaning Their immune system is weakened those particular patients are now susceptible to these microbes that normally don't cause
disease and so we're starting to see more of a trend of these diseases that are caused because of weakened immune systems we also are starting to see a big increase in microbes that are resistant to drugs Certain types of conditions were once fairly easy to treat an example of this would be gonorrhea which is a sexually transmitted infection this historically was relatively easy to treat if you got gonorrhea you took an antibiotic problem solved however we are starting to see multi-drug resistant strains of Neisseria gonorrhea which is the organism that causes gonorrhea and so what
was once an easy to treat sexually transmitted infection is now very difficult to treat because the bacteria has become resistant to many of our antibiotics so now we're going to move on and talk about naming and classifying microorganisms so in order to do so we need a few terms so the first term is going to be Taxonomy and taxonomy is going to be the science of classifying living things so basically how we're going to group different types of micro organisms or different organisms in general when we talk about nomenclature nomenclature is the assignment of scientific
names to the various taxonomic categories and to the Individual organisms so again nomenclature think name it's naming things classification classification is the orderly arrangement of the organisms into a hierarchy you will see that we will talk about classification schemes where we start with domain being the most broad form of classification working our way all the way down to species which is going to be the most Specific identification is the process of discovering and recording traits of organisms so that they can be placed into an overall taxonomic scheme and so it's important that we figure out
what are these characteristics that group different organisms together so when we talk about nomenclature again nomenclature or naming of organisms Was established in 1735 by carolus linnaeus and when he named these organisms the names were latinized they're latin one of the nice things is you'll start to see trends in the way that organisms are named and there are things that you can learn about an organism simply by their name and you'll see this in a minute So when we look at how organisms are named they have what's called a binomial nomenclature binomial means two names
the first of the two names is going to be the genus you need to capitalize the genus the second of the two names is going to be the specific epithet or the species when we write this this is going to be Lowercase so genus is capitalized species is lowercase both names are underlined separately so if you're hand writing the organism name you will underline it separately or it's italicized if you type it now if you're handwriting don't try and hand write it looking like italics that doesn't work if you hand write it you should underline
genus and species separately So if you think about humans for example and we think about our binomial nomenclature our two name name our name would be referred to as homo sapiens and so notice when i wrote it the genus the h is going to be capitalized species is going to be sapiens that is going to be lowercase and notice because i hand wrote it i underlined the genus and Species separately i don't just draw a line across i i underline individually so if we look at the way that organisms are named they may be descriptive
meaning they may tell you something about the organism themselves or they may have a name that honors the scientists who discovered it so for example escoricia coli escherichia coli honors the Discoverer theodore esrich so that's the esoritia coli is going to be used to describe the bacterium's habitat so if you think about coli what part of the body do you think that refers to and that is the colon which is the large intestine and so e coli is the type of bacteria found in the gut and it is part of your normal Flora in terms
of bacteria that's in your gut and so the coli the species name is going to describe the bacterium's habitat so again e coli is going to be found in the colon or the large intestine now we could also have staphylococcus aureus staphylo refers to what we call the arrangement meaning the way the organisms are Arranged in this case they are clustered what we call staphylo so staphyloe refers to grape-like clusters the caucus or cocci which is plural is going to refer to the morphology or the shape this bacteria is spherical or round so when we
look at staphylococcus aureus and we look at it under the microscope it's round or spheres and they're Grouped into grape-like clusters that's their arrangement so that's the genus aureus is used to describe the gold colored colonies because if you know the atomic symbol for gold it's au so if you look at staph aureus growing on a plate the colonies have this golden yellow color it produces this pigment that makes the bacteria to appear yellow and that's where the aureus comes from It comes from the golden color of that particular bacteria and so you'll notice that
these organisms their names actually tell you something about that organism where they're found what they might look like who discovered it etc so when we write out organism names the very first time we describe it let's say in a paragraph We have to write out the genus and species you don't abbreviate the very first time you have to fully write out the genus and the species however if you continue to talk about that organism then you can abbreviate the genus so let's take a look at this so if this is what i'm writing a ceresia
coli and staphylococcus aureus are Found in the human body so notice that they're italicized because they're organism names and when we write them out the first time they have to write out the genus and the species however if we continue to talk about those organisms let's say it says e coli is found in the so notice that the genus is now abbreviated we don't have to Continue to write out aceresia coli so e coli is found in the we said colon or intestine and s aureus again we can abbreviate the genus because we already mentioned
it in the sentence before staphylococcus aureus is found anybody know where staphylococcus aureus can be found answer is skin it's a type of bacteria that's found on the skin So we can write s aureus is found on the skin so again first time we talk about it we need to write out genus and species when we continue to talk about that organism we can then abbreviate the genus and simply write out the species so we can't simply just say without saying essaricio coli first we can't just simply write e coli because there are more Organisms
than esoricia coli there is a protozoan for example that is entamoeba coli so if i were to write e coli am i talking about entamoeba coli am i talking about aceresia coli so the first time you have to write out the genus and the species after that then you can abbreviate the genus with the capital letter period and then the species in lower case so we have remember classification Meaning the way that organisms are grouped and so our current system was proposed in 1978 by carl woos and the way that he classified organisms was different
than the way this had been done historically and what i mean by that is that the way that organisms used to be classified would be simply by looking at the organisms Okay well these organisms look alike so they must be classified together and these organisms there's more diversity they must be classified separately but if you think about it one of the things that if you think about humans for example we are all one species meaning the most specific form of classification physically right there's a lot of variation between people So we can't just simply look
at things as a good way to classify organisms and so our current system this what we call three domain system was classified by looking at ribosomal rna and so this ribosomal rna is a type of rna that's found in the ribosome which is an organelle that's used to produce proteins and so if they compare the sequences of these ribosomal rnas The more in common meaning the more similarities between their sequences the more closely related they are the greater the number of differences in the ribosomal rna that means that those organisms are more diverse they're more
distinct and they evolved from each other a lot longer ago in our evolutionary history and so they can use this ribosomal rna in order to Classify organisms now in our current system we have a three domain system and our three domain system is bacteria archaea and eukarya bacteria and archaea remember are both prokaryotic meaning that they lack that membrane-bound nucleus organisms that are in the domain eukarya are eukaryotic meaning they're made of eukaryotic cells Now domain is the most broad form of classification then we become more specific and our next classification is going to be
our kingdom so broad our domain is going to be eukarya then we can start to group organisms by kingdom and so historically we've had this four kingdom system protis or protista fungi plantae plants animalia Animals those were typically classically our four kingdom system however this system is constantly changing and evolving and that's because protists the way that an organism was classified as being a protist was that it was a eukaryotic cell but it wasn't a fungus an animal or a plant so it didn't meet the criteria to be any Of those three but it was
still eukaryotic so they put all of those organisms in protista think about if you have a junk drawer in your house so like i have a drawer that if you know guests are coming over to my house and i'm trying to clean up quickly i throw stuff in that drawer right i put it in there and i say i'll deal with this later that was like kingdom protista that was Scientists way of saying we don't know what to do with these organisms all we know is that they're eukaryotic but they're not plants animal or fungi
so we're going to put them in this other category we're going to put them in this kingdom protista and we'll deal with that later and so what they found was that a lot of the organisms that were classified as being Protists were actually fairly diverse and that wasn't really a great way to classify those organisms so that kingdom protista which has been around for a while is now being reclassified and it's being separated into multiple kingdoms so you'll probably see over the next you know several years that This is a constantly evolving and constantly changing
way to classify organisms it changes all the time so if we talk about protists this could be things like slime molds algae protozoans right think of algae and protozoans they are very different from one another algae are more plant-like protozoans are more animal-like so Putting them together not necessarily the best system which is why these are being separated now into more kingdoms if we talk about fungi so fungi would be your molds mushrooms and yeast molds and mushrooms remember are going to be multicellular yeast is going to be unicellular but they share certain characteristics together
like composition of their cell wall the fact that they are heterotrophic Many are saprobes they feed by dead decaying matter etc so those would be our fungi plants you can think of a lot of different plants so we have something as simple as a moss a moss is a very primitive plant it lacks a vascular system and so this is why mosses grow low to the ground they have to get nutrients and they have to get water by simple diffusion they're not like the Other plants ferns then evolve to have a vascular system but they
still don't use seeds for reproduction they use spores conifers so these are cone bearing plants think of like a pine tree for example that would have cones on it those plants can grow tall because they have a vascular system and they now reproduce with seeds the Seeds are contained within the cones and then lastly we have our flowering plants what we call our angiosperms these are now plants that evolved to have seeds but the seeds are now encased within a fruit and that helps because that fruit attracts animals to eat it animals will ingest the
seeds and animals are modal they'll move To a different area they will defecate out comes the seeds and it helps with seed dispersal flowers are an adaptation to help with pollination right to have pollinators to help pick up pollen from one plant and put it on another and so those would be our plants animals you can probably think of a hundred different animals that you could put here and so if i look at different examples of animals We could have humans so we are animals dogs monkey octopus um insects corals sea stars sponges i mean
the list can go on and on animals are the last type of classification in terms of kingdom so if we look at what we call a phylogenetic tree we're looking at evolutionary relationships meaning how far ago did these organisms diverge into Separate classifications so if we look at this first ancestral cell line this first living cell that cell at some point during its growth acquired a mutation mutations or changes in the dna sequence and those changes can happen randomly well what can happen is is that those mutations those changes can then lead to two different
groups of organisms so if we look at the first split we have This blue and the red well the bacteria split from archaea and eukarya early on notice what's interesting is if you look archaea are more closely related to eukarya then archaea is to bacteria so even though they are both prokaryotic and even though they are both unicellular archaeas still have more in common with Domain eukarya than they do domain bacteria and so that's why they're shown this way where they diverged more recently relative to when bacteria split from both domain eukarya and archaea so
if we look at domain bacteria we have our endospore producing bacteria bacillus clostridium etc we'll learn a lot about endospores we have our chlamydias which have to Grow within cells we have gram-positive bacteria like for example streptococcus pyogenes which causes strep throat we have blue-green bacteria we have recedias the different types of bacteria can be very diverse if we look at domain archaea we have our methane producers we have our halophiles the ones that live in extreme salt We have our thermophiles the ones that live in extreme heat if we look at domain eukarya these
are again going to be made of eukaryotic cells and so within domain eukarya we can have our four kingdom system plants animals fungi protists and then we can keep classifying and getting more specific as we move through this hierarchy so when we talk about our classification these can be arranged into several Descending ranks beginning with the most general meaning the most diversity within this category and ending with the smallest or the most specific so our classification in order is domain kingdom phylum class order family genus species and so the way that i remember our classification
scheme is that i think of this sentence and the sentence that i remember to help me keep This in order is i remember do keep pots clean or family gets sick so notice that the first letter corresponds to the classification the do is for domain keep is for kingdom pots is for phylum etc one of the things that you're gonna figure out is that having these mnemonic devices these ways to help you remember things is gonna make it a lot easier on Yourself it's a lot easier to remember do keep pots clean or family get
sick than it is to remember specifically domain kingdom phylum class order etc so throughout the semester you'll see that i will try and give you as many mnemonic devices or ways to remember things i am a very visual person i need to think about it in a way that will make sense to me and makes it easier to Recall and so i try and share those with you throughout the semester to help you remember certain things i teach you my little tricks for how i remember these things so if we look at our classification and
go through an example again our most broad classification would be our domain so if we're looking at kingdom animalia what domain did that have to be in was that in domain bacteria Archaea or was it in eukarya answer was the domain was eukaryote these are made of eukaryotic cells and so our domain is going to be again the most broad so domain is eukarya then we get to kingdom animalia so remember that within domain eukarya we have our plants we have our fungi we have our animals so domain is very broad now we're getting the
kingdom and we're getting more specific so now kingdom Is going to be animalia or the animals so now the plants are out the molds mushrooms and yeast are out the protists are out because those are not within kingdom animalia in kingdom animalia you can see in this example we have our fish we have our worm a bear cat lion butterfly mice right so those are kingdom animalia they're still very broad but we've already ruled out some Other organisms then we have our phylum our phylum in this case is going to be chordata chordates have what's
called a notochord and a notochord is a precursor to a vertebrae essentially and so notice that when we get into phylum chordata the worm is out the butterfly is out those don't have that notochord so the fish is still in play The bear is still in play the cats are still in play the lion is still in play and so is the mouse those all have that notochord which can serve as a precursor for a vertebrae we get more specific we get our class class in this case is going to be mammalia mammals these are
organisms where the females have mammary glands to feed Their young essentially meaning they can breastfeed their young they also have hair so the fish is now out it's not a mammal but we do have our bear we have our cat we still have our lion and our mouse so notice that as we go down this classification scheme we become more and more specific then we get to the order in this case the order is Carnivora carnivores now the mouse is out then we get down to family getting more specific feel a day think of felines
the cats so the bears out then we get to genus and the genus in this case is going to be felis so the felines those are going to be more specific to the cats now the lion is gone and then we get to our species and the Organism is referred to as felis domestica notice that the binomial name has the genus first it's capitalized species is second it's lowercase so our species is felis domestica so think of kind of like our house cats so notice that when we classify living things we go from the most
broad to the most specific and the most specific is going to be the species So now we need a definition for species so the biological definition of a species is going to be a group of individuals that have the ability to breed and produce fertile offspring so it has to meet both of those criteria so what does that mean has the ability to breed and produce fertile offspring so for example a donkey and a horse if a male donkey mates with a female horse They will give rise to what we call a mule a mule
is what we call a hybrid it's a mixture of the two now the mules are infertile they're not able to give rise to more mules so that's why horse and donkey are separate species yes they have the ability to breed but they don't produce fertile offspring so they're not the same species they're Separate species so that is kind of your definition of what a species is now does that apply to everything the answer is absolutely not think about organisms like bacteria they have a species but we can't use this term or this definition to help
define a species because bacteria reproduce asexually they simply make a copy of Themselves so we can't describe them in a way that says that they have the ability to breed they don't actually breed at all they simply just make a copy and so this is kind of this overview of what a species is but again recognize that this doesn't apply in every instance and similarly if a person is infertile meaning they're not able to have kids for whatever reason Does that mean that they're not part of the human species no it means that as a
group humans or homo sapiens or of the same species because as a group we have the ability to breed and produce fertile offspring so next we're going to walk through a brief history of microbiology and so ancestors of bacteria were the first life on earth so 1665 Robert hook who was an englishman observed a thin slice of cork through a relatively crude microscope and he reported that living things were composed of little boxes or cells as he called them think of like more like a cell in terms of a prison it's like a cell and
that's that then led To what's referred to as the cell theory that all living things are composed of cells and come from pre-existing cells so he was the first one to see cells however the cells that he saw were not from living organisms because cork is not alive so he studied household objects he studied plants trees and he described cellular structures and drew sketches Of little structures that seemed to be alive now anton van leeuwenhoek 1673 and 1723 was the first to describe living microorganisms what he called anima animocules little animals and so what he
did was he looked at different specimens like rain water feces scrapings from teeth and basically he did this using this primitive Microscope that you see here so it has this little pin where you can put the specimen it has a lens and so he would take those samples he would take the rain water or the scrapings from the teeth etc would put him on this pin use this lens and he would view those samples and so he did these little drawings of the different things that he saw and so what he saw was he saw
these Little rods he saw little spheres he saw a great diversity of different types of cells in these specimens that he found and so he was the first to kind of see living microorganisms hook was the one to see cells first but his specimens weren't necessarily living anton van leeuwenhoek was seeing living cells so the way i remember this is Alphabetical order h comes before v so hook came first he was the first to see cells van leeuwenhoek was the first to see living cells so those are the people now in terms of the year
i'm not going to ask you years i will not ask you what year did robert hook describes cells that's not my point for putting these on Here the year is not important when you're studying i just put the year on there to give you an idea of how long ago these various discoveries were made but by no means do you need to memorize that so once they saw cells this led to a debate about how life arose and so there were two competing theories During this time one was referred to as spontaneous generation and that
is the hypothesis that living organisms arise from non-living matter that some vital force forms life and so in spontaneous generation the idea was you could go from non-living to living that was spontaneous generations spontaneously some vital force they didn't know what It was but some vital force they said allowed life to come from nothing biogenesis on the other hand is the hypothesis that living organisms arise from pre-existing life so in this case life gives rise to life so that life only comes from other pre-existing life so life begets life so life gives rise to life
so this was the theory of biogenesis now there was a debate for a period of Time some scientists believe in spontaneous generation others believed in biogenesis and so we're going to talk about several experiments that were done to see if biogenesis is the way or spontaneous generation is the way so 1668 an italian physician francesco reddy did an experiment using meat and looking at maggots and so what he did was he took meat And he put it in a sealed jar and what he was looking for was he was looking for did he see maggots
on the meat so if we put him in a sealed jar did he see maggots the answer was when the jar was sealed the meat was starting to break down but there were no maggots he repeated the experiment he now did an open jar so the lid is off with the decaying meat and what he saw Was that there ended up being maggots on the meat so the maggots on the meat basically they said this was in support of biogenesis life comes from life now antagonists of this experiment said well this experiment's not valid because
fresh air is required so that vital force can't happen without air getting in so they said that The one that was sealed it didn't work they didn't see life because air is required so to squash that theory he did a follow-up experiment a second experiment where instead of sealing it so no air gets in he covered the top with a netting so air can get in but the flies can't get in to lay their eggs because the maggots are the larval form Of the fly so if the fly can't get in to the meat are
we going to expect to see maggots on the meat the answer is no because if the flies can't get in there they can't lay eggs and they can't form the maggots so no maggots basically helps to suggest that it is biogenesis life comes from life and so this experiment helped provide evidence in support of Biogenesis now it's important to note that with any scientific theory you can't prove a scientific theory you can provide evidence in support of a particular theory you can provide evidence to falsify another what we call an alternative hypothesis etc but we
can't ever prove a theory we can just say that the alternate Hypothesis is not possible so in this case it's basically ruling out spontaneous generation that life can't just come from life so people still didn't believe that based on freddie's experiment and so they said well you know maggots yeah yeah maggots can't come from nothing that's too advanced that doesn't work but things that are More simple could still do spontaneous generation so in 1745 an englishman by the name of john needham boiled nutrient broth and then covered the flask so we have this broth this
nutrient-rich media and he boiled it to kill off any microbes and then after boiling it then he covered it And what he saw was that when he looked days later that there was bacterial growth in the flask so the bacteria grew in that flask so what do you think which which theory do you think that he suggested this shows did that show spontaneous generation or biogenesis and his conclusion based on this experiment Was that it was spontaneous generation that life could come from nothing right he boiled it he thought well i killed off the bacteria
and then i covered it and somehow the bacteria grew so that must be that spontaneous generation can occur that you can get growth from nothing however it's simply because of a problem with the way that he designed his experiment So if you're to think about this if you boil it right and the top is still off and then you cap it right then you cover it where do you think those microbes came from and the answer is they came from the air they fell into the flask after the broth was boiled right so because of
the way he designed his experiment his experimental design was flawed and That's because he capped it after so bacteria already had a chance to fall in after the broth was boiled so 1765 uh lazaro spelanzani who was an italian scientist said that needham should have covered before boiling so to protect the microbes from the air from falling in so he repeated this experiment he capped it first Then he boiled it right so notice that nothing can fall in what do you think his result was what do you think he saw as his outcome the answer
is he saw no growth so he saw no growth that's because by covering it first and then boiling the boiling is going to kill off any microbes and now because it was covered before the boiling nothing could fall in and nothing could grow so is this Experiment in support of spontaneous generation or biogenesis answer is it's in support of biogenesis life comes from life so he argued that by doing the experiment this way that that is why uh you didn't see anything growing because nothing could fall in which shows that life only comes from life
but antagonists were still not convinced with this experiment to say that it was Biogenesis they said well that boiling that you did destroyed that vital force so that's why you didn't get any growth you didn't get any growth because you destroyed the vital force we know that's not true but that was what was believed at the time so there was another experiment after this 1861 louis pasteur did an experiment using this s-shaped Flask so what he did in his experiment was he took this broth and he poured it into a flask so he took this
non-sterile liquid this broth and poured it into the flask now he used a flame and he bent the glass so that it had this s-shaped neck so notice that when he did this and his he created this s-shaped flask This is open air can still get in but anything that comes in is going to settle in the neck here of the tube and is it going to be able to grow and the answer is that if you boil that liquid right you're boiling that liquid you're killing off any microbes that could be in the broth
air can still get in so would you expect to see growth and The answer is that he did not see growth right that's because the dust and the microbes got trapped in the neck of the flask where it bent and it never was able to get up and into the broth and so therefore it didn't grow and so even when these flasks set for many many years still nothing grew And so when he has his nutrient broth placed in our his s-shaped flask he heated and it wasn't sealed he saw no growth so is that
in support of spontaneous generation or biogenesis and that is that this evidence is in support of biogenesis life comes from life the air can get in so we can't say it's no air that's preventing the growth right and then he did follow-up Experiments to show that in fact that it wasn't just the act of heating the liquid that caused the microbes to not grow it was more than that and so let's take a look so i have a class paper this is going to be something you want to answer ahead of time and then we
are going to discuss it during The discussion section so class paper if you break the s-shaped neck so pasteur did his experiment he boiled the liquid right and then if you were to break the s-shaped flask so to break it right so if you break it and things can fall in i want you to predict would you expect to see growth why or why not right so if you were to break it would you Expect to see growth why or why not the second part of this is if you were to tip the flask over
so that now the broth goes into the neck and then you put it right side up meaning you put it back standing up would you expect to see growth why or why not so you want to think of your answer and during the discussion we will discuss this together and so based on the results of these Experiments and the one that we will talk about later 1861 louis pasteur microbes in the air can contaminate but the air does not create the microbes because the air could get in however when he had as a shaped flask
he did not get growth in that flask so the air did not create the microbes the microbes came from if they fell into the flask And so he was credited largely with disproving spontaneous generation again we can't say that he proves biogenesis but he disproves the alternative hypothesis so he disproves spontaneous generation pasteur was also credited with aseptic technique so techniques that are used to prevent contamination by unwanted microbes and so if you think Of pasture you probably think of pasteurization right so using heat to reduce the number of spoilage microorganisms to make milk let's
say for example more safe to drink and so pasteur really revolutionized microbiology and really started to understand this aseptic technique how do you prevent from transferring microbes from one place to another So question for you which of the following statements is the best definition of biogenesis red non-living matter gives rise to living organisms yellow living cells can only arise from pre-existing cells green a vital force is necessary for life blue air is necessary for living organisms purple microorganisms can be generated from Living non-living matter so pause your video think of your answer when you're ready
push play and so the answer is going to be yellow best definition of biogenesis is that living cells can only arise from pre-existing cells so life gives rise to life it's not red non-living matter can give rise to living organisms that would be our spontaneous generation It's not green a vital force is necessary for life again that's associated with spontaneous generation air is necessary for living organisms that is not true while some organisms like us do require air other organisms are what we call anaerobic they grow in the absence of air so air is not
necessary for living Organisms and purple says microorganisms can be generated from non-living matter again that would be our spontaneous generation so between 1857 and 1914 this was considered the golden age of microbiology and so there were rapid advances in the field by both pasteur and another scientist by the name of robert cook now that last name koch Can be pronounced a variety of ways some people will say cook some people will call it koch some people will call it coke it just depends on who you're talking to there's not necessarily a right or wrong way
that name could be pronounced any of three ways so i'm just gonna go with cook but again that doesn't necessarily mean the others are wrong it just depends on how somebody Pronounces it so i'm going to say robert cook now during this period of time microbiology was really starting to be established as a science so pasteur pasteur wanted to know why did beer or wine sour he wanted to know what made it go bad well yeast converts sugar to alcohol without air that process is referred to As fermentation so if you grow yeast in anaerobic
conditions meaning without oxygen they will do alcoholic fermentation and they will produce alcohol however if that wine for example or beer is exposed to air the alcohol is then converted to acetic acid by any bacteria that can get in there so any bacteria that might be present Is going to take the alcohol and convert it to acetic acid acetic acid think of vinegar it's going to make your beer or wine taste sour because of that acetic acid being produced pasteur demonstrated that these spoilage bacteria could be killed by heat that was not hot enough to
evaporate the alcohol in the wine but was enough to reduce the number of microbes In the wine that it wouldn't cause the wine to sour and so this technique was then referred to as pasteurization that's the application of a gentle heat for a short time and the gentle heat will kill most bacteria but it won't cause the wine to evaporate and so he really helped to understand about again this aseptic technique so what could be done To prevent contamination from unwanted microbes 1840 we have ignace simelweis who was a hungarian physician so this hungarian physician
noticed that doctors would do dissections of cadavers in the morning and then not wash their hands and would deliver babies because at this time doctors were thought to be this these superior people and that they Were just inherently clean and so they would do their dissections in the morning of the cadavers and then would not wash their hands and would deliver babies and as a result there was a high incidence of death from something called childbirth fever however midwives do not do or did not do dissections they weren't involved in Dissections and when there when
the midwives would deliver the babies there was a lower incidence of death from this child birth fever and he wondered why was it that when these midwives delivered the baby why was the incidence of child birth fever less than if the physicians were to deliver the babies and so this Childbirth fever results from what's called septicemia which is bacteria in the blood and so he noticed that the doctors had this higher incidence of this childbirth fever and so some always concluded that some unknown cadaverous materials caused the childbirth fever and he instituted a policy of
using a solution of chlorinated lyme for washing hands between Autopsy work and the examination of patients and he did this because he found that the chlorinated solution worked best to remove that putrid smell of the infected autopsy tissue and thus perhaps destroyed this casual poisonous or contaminating cadaveric agent and so because this chlorinated lime basically would get rid of the smell he Said well that likely means that it's also getting rid of this cadaverous material which could then also reduce the risk for childbirth fever so what happened was was that he basically was somebody who
really advocated for hand washing between patients he said that doctors should wash their hands after doing Autopsies now people did not believe him at this time he was ahead of his time people did not believe him and they thought he was crazy he was committed to an asylum and died after being admitted by a beating by a guard so poor soma weiss you know was telling people you know wash your hands wash your hands and they pretty much persecuted him for this belief and said no Physicians are clean it's not necessary and put him in
an asylum and then he was killed in this asylum we'll come to find out once they started washing their hands the incidence of child birth fever dropped from 35 percent to 1 percent so some of weiss was right they did need to wash their hands between patients they needed to clean their hands after working with the cadavers 1860s we have joseph lister who was a surgeon he applied the germ theory to medical practices and he cleaned the instruments in between surgeries he knew that fennel or carbolic acid killed bacteria and so he used that carbolic
acid as a chemical control agent basically to disinfect the surgical equipment between surgeries 1875 robert cook he was a german physician and he came up with what's known as cook's postulates and these are a series of logical steps that establish whether or not an organism is pathogenic meaning it causes disease and which disease it causes and he basically supported or provided evidence to show that bacteria do in fact cause Disease this led to the germ theory of disease he discovered bacillus anthracis from a cow that died of anthrax so he was the one to discover
this particular type of bacteria so let's talk about how cook's postulates work so what happens in cook's postulates is that he took a organism from a dead animal so let's say he had this myos and the mouse Died and he isolated microbes from the dead animal so they're grown into a pure culture where there's only one type of bacteria there they would then identify those microorganisms so see what types of microbes were present and then they would take that pure culture and inject it into a healthy animal if the injected animal the healthy Animal now
dies of the same disease that the previous mouse had and then they looked to see if they culture the bacteria the microbes from the mouse that now just died if they then culture that and they study that if that pathogen is the same as the initial one then you can say that that particular Microbe causes the disease because when you injected that into a healthy mouse that mouse then died of that same disease so obviously that microbe must be responsible for that disease and so there are several rules that have to be met in terms
of cook's postulates one the same pathogen must be present In every case of the disease so when you isolate from the mouse that died the one that was injected you have to have the same pathogen in every disease in each every case of that disease the pathogen must be isolated from the diseased host and grown in pure culture the pathogen from the pure culture must cause the disease when it's inoculated into a healthy Susceptible laboratory animal so again in step two they isolated the bacteria and then they inject it into a healthy host and you're
looking for does it cause disease and the last part of this is that the pathogen must be isolated from the inoculated animal and must be shown to be the original organism so that's the step five so if you take That organism that died the one that you inoculated and now you take it and you look at the types of microbes that are present if this is true if that particular microbe causes that disease you need to see that same microbe at the end that you saw in step two that would show that that microbe is
the one that's responsible for causing the disease 1796 we have edward jenner edward jenner was basically one of the first to develop a vaccine and one of the things that he noticed was during this time smallpox was a very deadly disease however he noticed that milkmaids didn't tend to get smallpox however they did get cow pox from working with the cows and when they got this cow pox it was much milder it didn't have the same severity that Smallpox had but those milkmaids didn't contract smallpox and so he wondered well why do these milkmaids not
get smallpox and so what he then did was he scraped lesions from a milkmaid that had cowpox so she had cow pox they he scraped some of the lesion from the cow pox and then injected that into a healthy Child and that healthy child was his own child can you imagine that happening now no nobody is injecting my kid as an experiment but this was a different time so he exposed a healthy individual to the material from the cowpox lesion and so the child then developed the cow pox came down with a more mild form
of the Disease and then exposed the child to smallpox and found that when exposed to smallpox that the child did not contract smallpox so something about the cowpox provided protection against the smallpox and this protection from disease is provided by vaccination and it's referred to as immunity right and if you have immunity it means that you are protected Against that disease so think about what's going on right now in the world right if you think about the coronavirus the hope is that at some point we have a vaccine because if we can inject material from
the coronavirus enough that it doesn't make us get sick with covid but it still causes us to mount an immune response and that immune response then protects us from getting that disease That's the whole idea behind the vaccination now in the case of covid we still don't know whether or not if you get the disease if you're even protected so meaning even if we were to vaccinate do you get immunity by the vaccine does it provide short-term protection does it provide long-term protection etc but the idea behind a Vaccination or a vaccine vaca comes from
cow cow pox the idea behind a vaccine is to inject either a weakened form of that organism or just a part of that organism just so that it elicits an immune response but not enough so that you come down with the disease itself and so he was largely credited with The first vaccine to be developed by doing this particular experiment 1880s pasteur discovered why vaccinations work and so he noticed that cholera bacterium lost the ability to cause disease after being grown in the laboratory for long periods however that bacteria was still able to induce immunity
so while that bacteria itself was no longer very virulent if Somebody came in contact with that weakened strain that was still enough to induce immunity to protect against cholera the disease 1928 alexander fleming discovered the first antibiotic and this has to be the most lucky discovery in the history of discoveries this happened completely by accident so alexander fleming was trying to grow Bacteria and he ended up with this contamination on his plate and this contamination had this fuzzy appearance and he noticed that where this fuzzy stuff was growing bacteria was not so something in that
fuzzy material was inhibiting bacterial growth we now know that fungus is a fungus called penicillium Penicillium you can guess produces penicillin so this fungus is producing the penicillin which is inhibiting microbes from growing in the area and so it killed the staph aureus that he was trying to grow on his plate and therefore this was how penicillin was discovered it was completely on accident he did make a good a good intuition where he noticed that the Fuzzy stuff inhibited bacteria from growing which then led him to further investigate but this was a pretty lucky discovery
now penicillin was discovered in 1928 but it wasn't mass produced and tested clinically until approximately the 1940s so it took quite a while for it to become kind of mainstream So the other part that's going to be part of your class paper meaning your assignment that will be part of the zoom is that you need to match the people to their contribution towards the advancement of microbiology so like for jenner number one you're gonna pick a letter that goes with jenner's discovery what did he do that advanced Microbiology and so you need to fill this
in and again in class when we discuss this you will discuss it with a group and go over your answers and so lastly we're going to talk about recent advances in microbiology so in the 1970s we had the discovery of restriction enzymes and so three scientists were the ones that are credited with the Discovery of restriction enzymes we have daniel nathan's we have werner arbor and hamilton smith and they discovered these little molecular scissors inside bacteria and these molecular scissors chop up dna in very specific ways and so this allows scientists to use these enzymes
to cut dna in certain ways to allow us to have that recombinant dna Technology so meaning like when we take the human gene and we want to put it into bacteria for bacteria to make human insulin well you have to have a way to get that dna sequence into the bacteria and so the way that that works is you use these restriction enzymes these enzymes from bacteria and you can use those enzymes to cut at very Specific sequences and that then allows you to mix dna sequences together till you get that recombinant dna this bacterial
plasmid that then has this human insulin gene on it and so this opened the floodgates to genetic engineering and basically has helped with the investigation into biological processes And the biological revolution of the 21st century so this was a really big discovery in the 1980s we have polymerase chain reaction so pcr pcr was a breakthrough in our ability to detect tiny amounts of dna and then amplify them into quantities that were sufficient for studying so you can think of pcr as essentially The dna xerox machine it allows us to make many copies of those dna
sequences this has provided a new powerful method for discovering new organisms so it allows us to detect if a particular organism is present so for example in one of the coronavirus tests that we have they use this pcr they're looking for these sequences In the patient's body that shows that the coronavirus is present and so they can do this by using this pcr so diagnosing infectious diseases so again like for covid and for forensic work such as crime scene investigation so this really basically helped for forensics because it allowed scientists to study or to basically
be able to detect Blood semen etc that was left behind at a crime scene in very small amounts but then be able to amplify those genetic sequences so that then they could study and figure out where did those samples come from whose blood was it whose semen was it etc that really couldn't happen well until pcr that was kind of a game changer in forensics because it allowed Scientists to amplify that dna so that even if they didn't have a lot left behind at a crime scene that they could still study it in the 2000s
we have these small types of rnas so genome sequencing has revealed that perhaps only about two percent of our dna actually codes for protein so a big chunk of our dna is not even there to code for proteins Much rna rna is ribonucleic acid doesn't end up with a protein counterpart and these pieces of rna are usually small and it now appears that they have a critical role in regulating what happens in the cell so they control how long the mrna hangs around for example and so it appears that they have A very critical role
even if they're not used to code for proteins because normally like mrna is used to code for proteins but these other small rnas even though they don't code for protein they still have a very important role and this has led to new approaches and how diseases are treated for example if the small rnas are important in bacteria that infect Humans they could then be new targets for antimicrobial therapies because these small rnas what we call small interfering rnas which are s-i rnas or m-i-rnas which stands for micrornas if we have those small rnas that target
a particular bacterial sequence that could be used to then help treat diseases and then we have the microbiome project and so this was done in the 2010s and beyond and so the first detailed information that was produced by the human microbiome project was astounding even though the exact types of microbes found in and on different people are highly diverse the overall set of metabolic capabilities the bacterial communities possess is Remarkably similar among those people so even if they had a unique type of bacteria in their body and you compared two people right person a and
person b they might have different bacteria between person a and person b but those bacteria that are present are doing something very similarly for the body and so this and other groundbreaking discoveries have set the stage for new knowledge of Our microbial guests and their role in the overall health and disease and so an interesting example of this was that they found that babies who were born via c-section so cesarean section versus babies that were born vaginally had very different types of bacteria as part of their normal flora they were influenced by the way they
were delivered Right because babies that come out of the vaginal canal are exposed to a very different subset of bacteria than babies that are cut out of the uterus right they're not coming in contact with those vaginal bacteria and they're actually finding that that vaginal bacteria is actually good for babies to help colonize and be part of their normal flora and so one thing that they're doing now Is to basically do transfers of that you know vaginal area onto babies that are born via c-section to try and recreate that natural normal flora that they should
have if they had come out vaginally there are lots of examples of this we can have what are called fecal transplants so for people who have a type of Infection in the gut called c diff clostridium difficile this is a type of bacteria that is very resistant and one of the ways that we can use or that we can treat this is by a fecal transplant by transferring feces from a healthy individual into the intestine of somebody who has c diff and the idea is that when you put those good bacteria in that they will
out compete the bad Bacteria and that could be used to then fight off this c diff infection and so a lot of research is going into this human microbiome project understanding what bacteria are present in the body what happens if you get disruption to that normal flora how do you get these different diseases like which bacteria are associated with obesity Right which ones are associated with um obsessive-compulsive disease etc and so this is part of that human microbiome project and so this concludes our first lecture